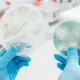

Atribuindo o devido valor à produção rural
Cristina Haberl
As pessoas estão cada vez mais preocupadas em se alimentar de forma saudável, em saber de onde vêm os alimentos e como são produzidos. Esta tendência de consumo de alimentos naturais, beneficia em muito a produção artesanal.
A elaboração em pequena escala, tem a vantagem de ser feita de uma forma diferenciada, possibilitando flexibilidade para produzir maior variedade e dispensa o uso de produtos químicos tão prejudiciais ao organismo.
Na produção industrial de alimentos é alterado artificialmente o sabor, aroma, coloração e para conservação é usada toda a espécie de aditivos químicos. O objetivo é reduzir custos, vender grandes quantidades em embalagens sofisticadas e atrativas, desenvolvida por profissionais especializados em atrair o consumidor.
Já na produção artesanal são utilizados equipamentos simples, as frutas e verduras são as cultivadas na propriedade, sendo oferecido um produto de qualidade, mais saudável, feito em pequena escala, onde o “artesão do alimento” pode usar toda sua criatividade para descobrir novas combinações de sabores.
Outro aspecto a ser destacado na produção artesanal é a valorização da tradição cultural, quer seja com as receitas passadas de geração em geração e que se identificam com o produtor rural, ou uma receita com característica especial de determinada região, representando uma atração para quem quer conhecer comidas típicas que possuem suas histórias. Quem não tem aquela receita especial secreta, feita pela Vovó e que todo mundo adora? Por que não adaptar e comercializar?
Cristina Haberl, farmacêutica, especialista em controle de qualidade, pesquisadora de produtos rurais e empresária
